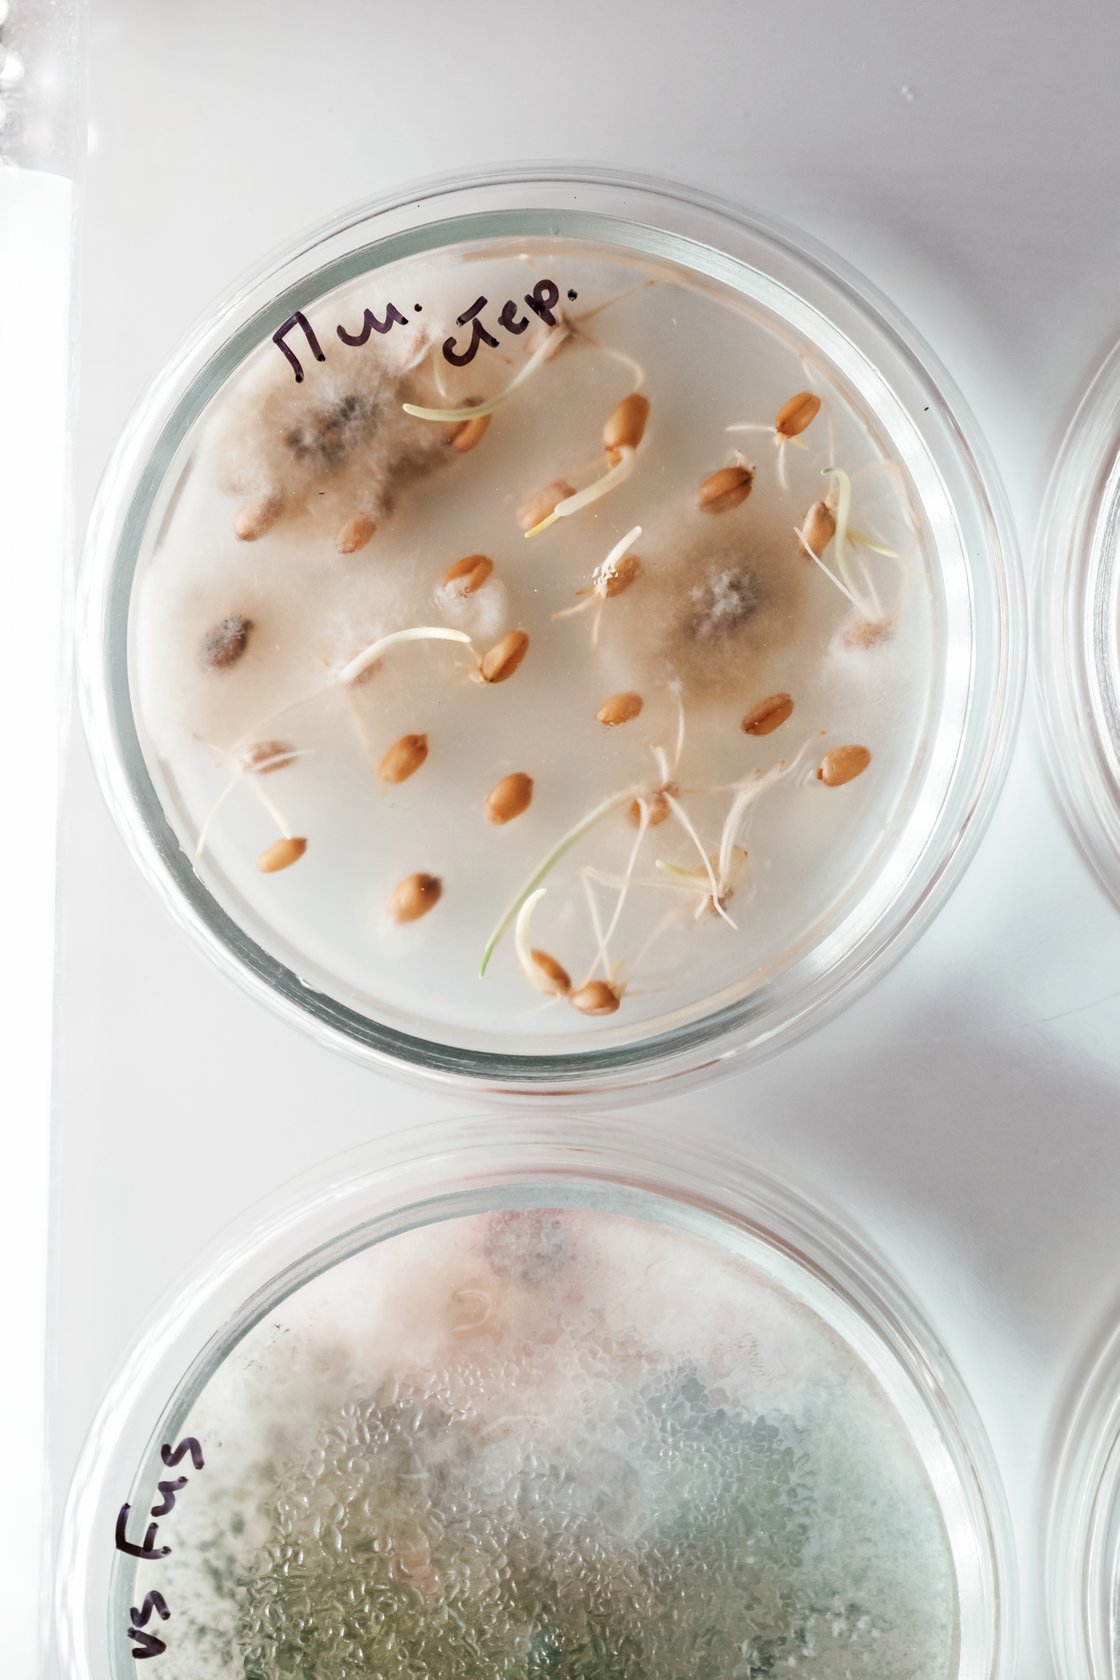
detailed-top-view-trichoderma-and-sclerotinia-in-2025-03-18-20-07-50-utc

Het gepatenteerde COMPLEX G5®
Het unieke van Alaena zit in de extracten van gekiemde zaden, die rijk zijn aan biomoleculen zoals aminozuren, peptiden en enzymatische cofactoren. Deze bestanddelen helpen de huidbarrière te herstellen, verbeteren de hydratatie en geven de huid opnieuw glans en veerkracht.
Het gepatenteerde COMPLEX G5® is ontwikkeld op basis van vijf zaden, waaronder chia, lijnzaad, tarwe, haver, groene soja, aangevuld met amarant en boekweit. Elk zaad levert zijn eigen mix van essentiële aminozuren, vitaminen en antioxidanten.
Het kiemingsproces
Tijdens het kiemen komen er micronutriënten vrij, waardoor het zaad verandert in een geconcentreerde bron van leven, rijk aan herstellende en voedende stoffen.
Naarmate we ouder worden, neemt de opname van vitale voedingsstoffen in het lichaam af. Via onze voeding bereiken bepaalde stoffen via de bloedvaten de huidcellen in de dermis, maar niet de epidermis (de buitenste laag van de huid) omdat die geen bloedvaten bevat. Alaena brengt deze biomoleculen rechtstreeks aan op het huidoppervlak dankzij extracten van gekiemde zaden.